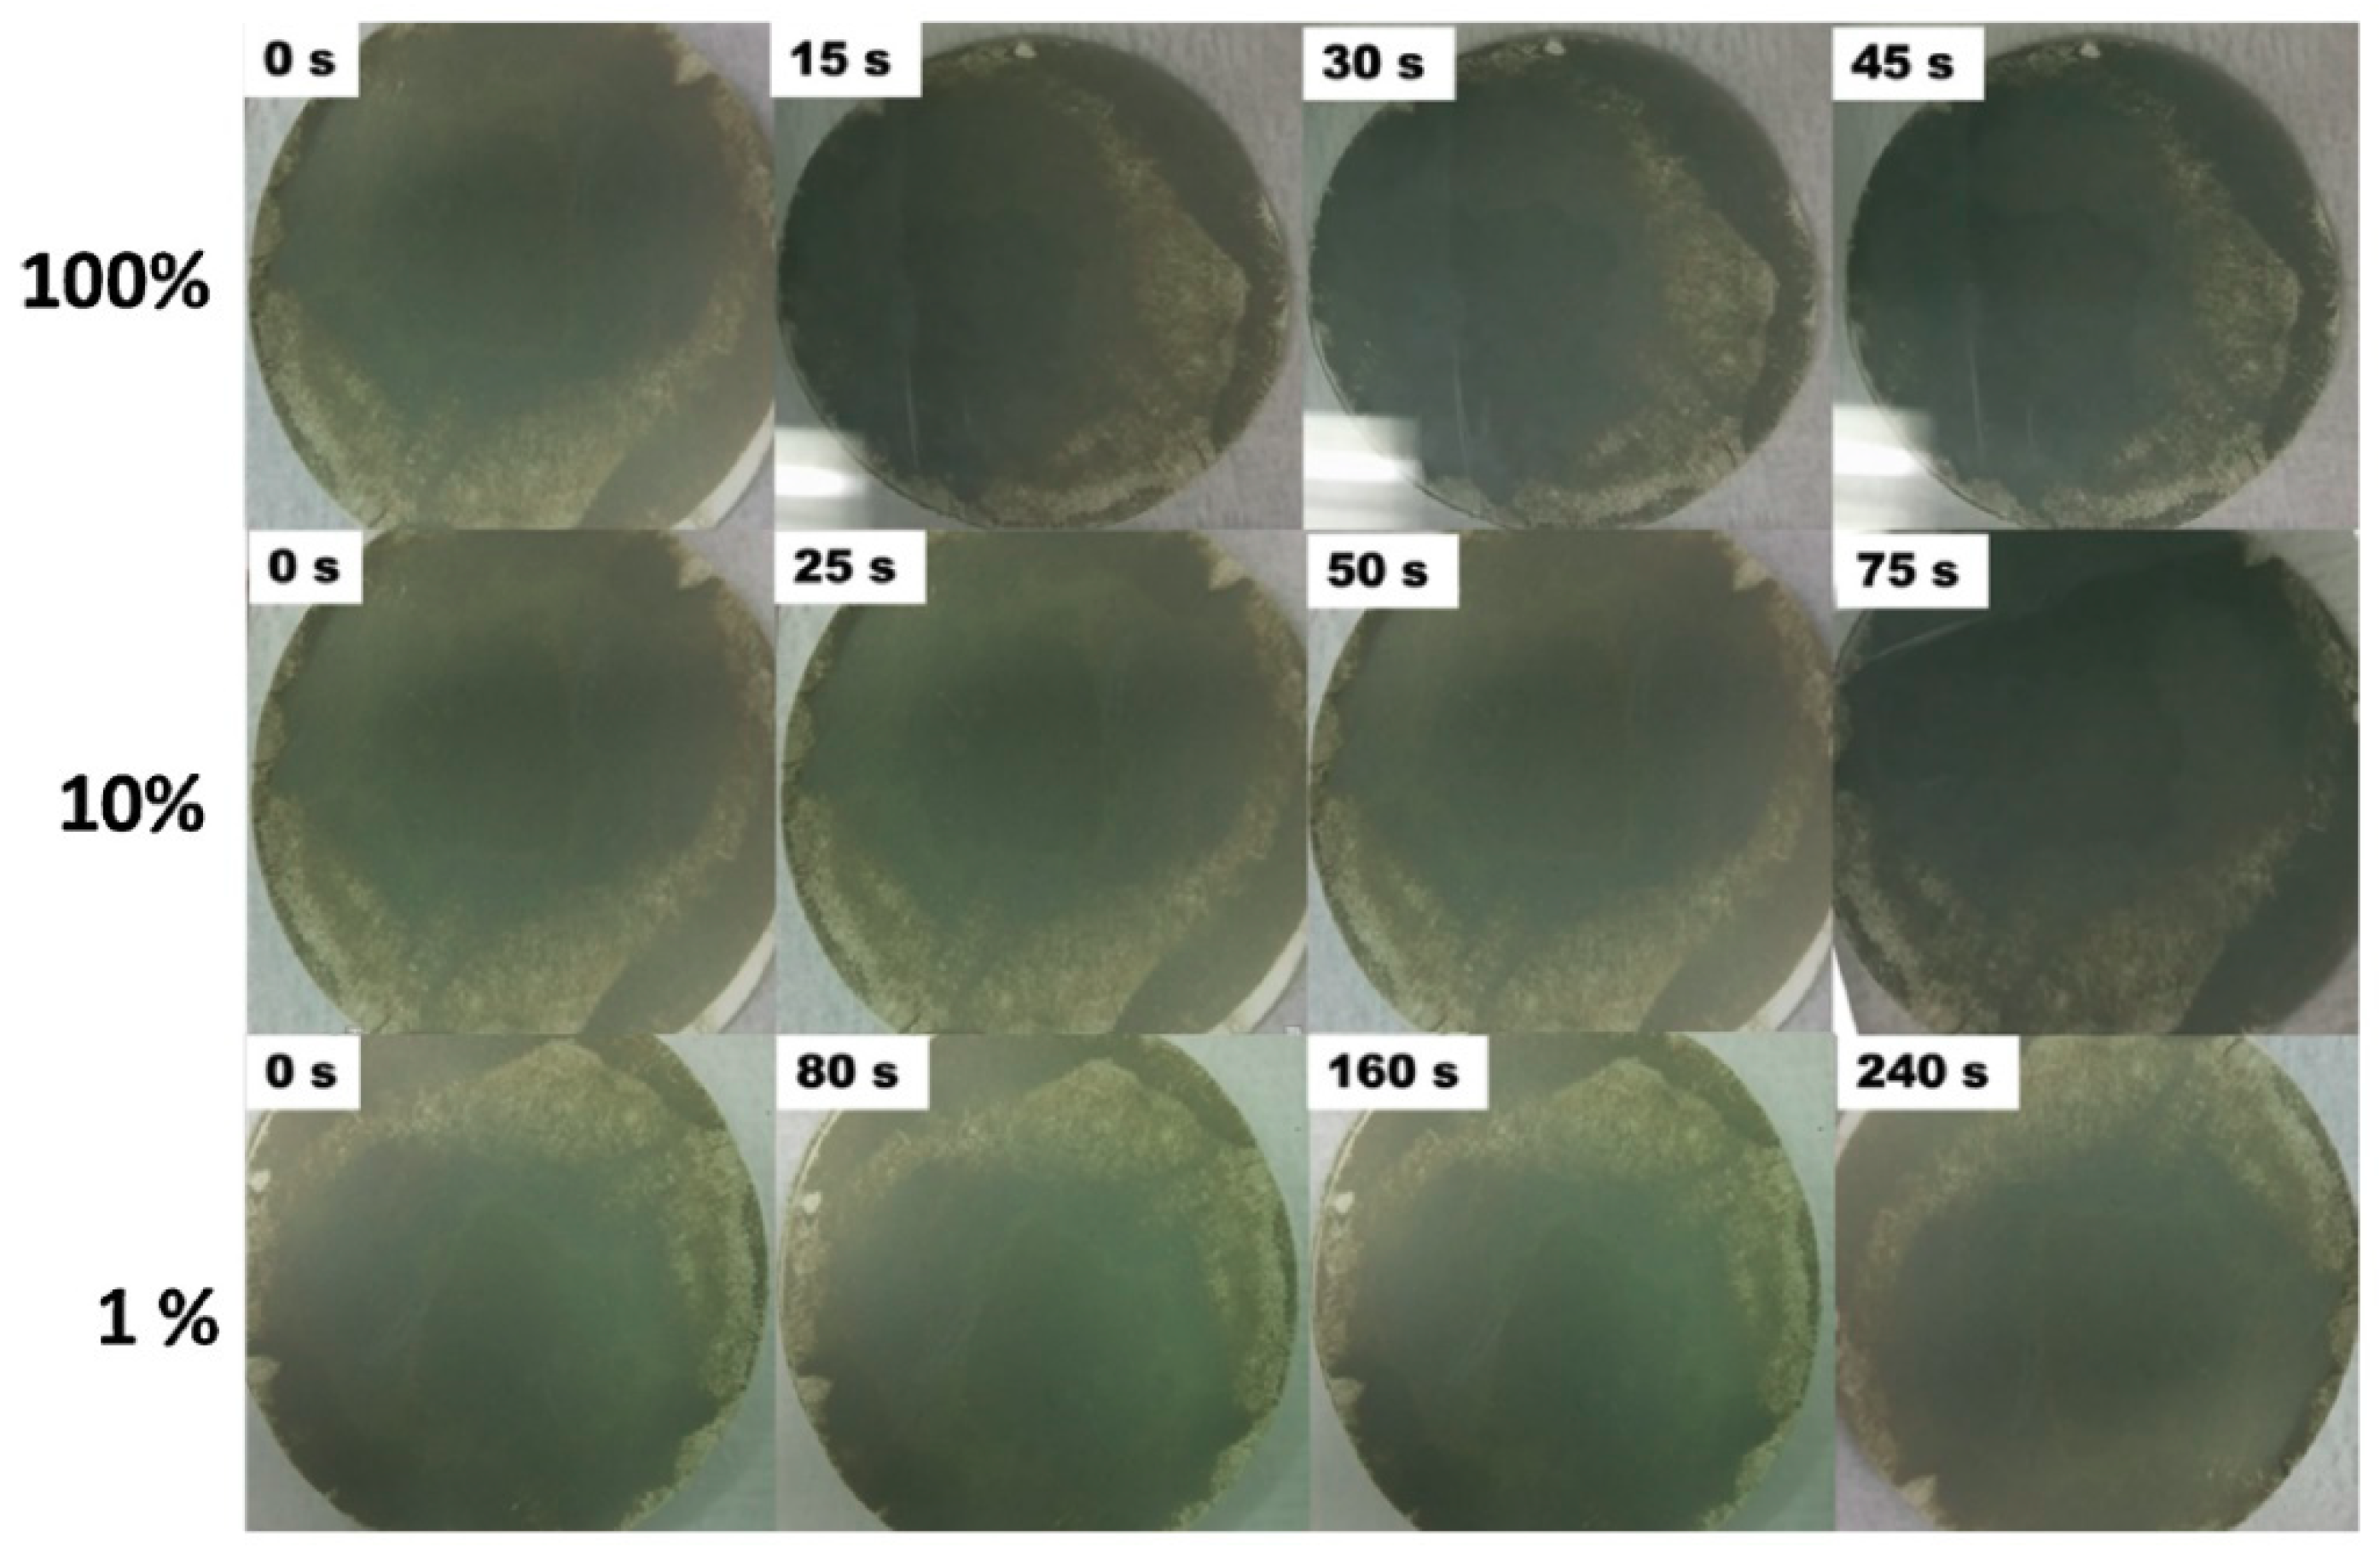
Applsci 09 01775 g008

Gasochromic WO3 Nanostructures for the Detection of Hydrogen Gas: An Overview
Abstract
:1. Hydrogen Gas
2. WO3 and Its Crystal Structure
3. Chromogenic: Definition, Materials and Basics
3.1. General Sensing Mechanism of Gasochromic WO3
3.2. Gasochromic WO3 Nanostructures as Hydrogen Gas Sensors
4. Conclusions and Outlook
Author Contributions
Funding
Acknowledgments
Conflicts of Interest
References
- Noh, H.-J.; Kim, H.-J.; Park, Y.M.; Park, J.-S.; Lee, H.-N. Complex behavior of hydrogen sensor using nanoporous palladium film prepared by evaporation. Appl. Surf. Sci. 2019, 480, 52–56. [Google Scholar] [CrossRef]
- Kumar, A.; Kumar, A.; Chandra, R. Fabrication of porous silicon filled Pd/SiC nanocauliflower thin films for high performance H2 gas sensor. Sens. Actuators B Chem. 2018, 264, 10–19. [Google Scholar] [CrossRef]
- Wu, C.-H.; Zhu, Z.; Huang, S.-Y.; Wu, R.-J. Preparation of palladium-doped mesoporous WO3 for hydrogen gas sensors. J. Alloys Compd. 2019, 776, 965–973. [Google Scholar] [CrossRef]
- Boon-Brett, L.; Bousek, J.; Castello, P.; Salyk, O.; Harskamp, F.; Aldea, L.; Tinaut, F. Reliability of commercially available hydrogen sensors for detection of hydrogen at critical concentrations: Part I-Testing facility and methodologies. Int. J. Hydrogen Energy 2008, 33, 7648–7657. [Google Scholar] [CrossRef]
- Sanger, A.; Kumar, A.; Kumar, A.; Chandra, R. Highly sensitive and selective hydrogen gas sensor using sputtered grown Pd decorated MnO2 nanowalls. Sens. Actuators B Chem. 2016, 234, 8–14. [Google Scholar] [CrossRef]
- Xu, B.; Li, P.; Wang, D.; Zhao, C.-L.; Dai, J.; Yang, M. Hydrogen sensor based on polymer-filled hollow core fiber with Pt-loaded WO3/SiO2 coating. Sens. Actuator B Chem. 2017, 245, 516–523. [Google Scholar] [CrossRef]
- Harley-Trochimczyk, A.; Chang, J.; Zhou, Q.; Dong, J.; Pham, T.; Worsley, M.A.; Maboudian, R.; Zettl, A.; Mickelson, W. Catalytic hydrogen sensing using microheated platinum nanoparticle-loaded graphene aerogel. Sens. Actuator B Chem. 2015, 206, 399–406. [Google Scholar] [CrossRef] [Green Version]
- Li, Y.; Li, X.; Tang, Z.; Tang, Z.; Yu, J.; Wang, J. Hydrogen sensing of the mixed-potential-type MnWO4/YSZ/Pt sensor. Sens. Actuator B Chem. 2015, 206, 176–180. [Google Scholar] [CrossRef]
- Sil, D.; Hines, J.; Udeoyo, U.; Borguet, E.J. Palladium nanoparticle-based surface acoustic wave hydrogen sensor. ACS Appl. Mater. Interfaces 2015, 7, 5709–5714. [Google Scholar] [CrossRef] [PubMed]
- Mirzaei, A.; Sun, G.-J.; Lee, J.K.; Lee, C.; Choi, S.; Kim, H.W. Hydrogen sensing properties and mechanism of NiO-Nb2O5 composite nanoparticle-based electrical gas sensors. Ceram. Int. 2017, 43, 5247–5254. [Google Scholar] [CrossRef]
- Kim, S.; Song, Y.; Lee, Y.-I.; Cho, Y.-H. Thermochemical hydrogen sensor based on Pt-coated nanofiber catalyst deposited on pyramidally textured thermoelectric film. Appl. Surf. Sci. 2017, 415, 119–125. [Google Scholar] [CrossRef]
- Hübert, T.; Boon-Brett, L.; Black, G.; Banach, U. Hydrogen sensors-A review. Sens. Actuators B Chem. 2011, 157, 329–352. [Google Scholar] [CrossRef]
- Ishihara, R.; Yamaguchi, Y.; Tanabe, K.; Makino, Y.; Nishio, K. Preparation of Pt/WO3-coated polydimethylsiloxane membrane for transparent/flexible hydrogen gas sensors. Mater. Chem. Phys. 2019, 226, 226–229. [Google Scholar] [CrossRef]
- Kabcum, S.; Channei, D.; Tuantranont, A.; Wisitsoraat, A.; Liewhiran, C.; Phanichphant, S. Ultra-responsive hydrogen gas sensors based on PdO nanoparticle-decorated WO3 nanorods synthesized by precipitation and impregnation methods. Sens. Actuators B Chem. 2016, 226, 76–89. [Google Scholar] [CrossRef]
- Mirzaei, A.; Leonardi, S.G.; Neri, G. Detection of hazardous volatile organic compounds (VOCs) by metal oxide nanostructures-based gas sensors: A review. Ceram. Int. 2016, 42, 15119–15141. [Google Scholar] [CrossRef]
- Mirzaei, A.; Neri, G. Microwave-assisted synthesis of metal oxide nanostructures for gas sensing application: A review. Sens. Actuators B Chem. 2016, 237, 749–775. [Google Scholar] [CrossRef]
- Mirzaei, A.; Hashemi, B.; Janghorban, K. α-Fe2O3 based nanomaterials as gas sensors. J. Mater. Sci. Mater. Electron. 2016, 27, 3109–3144. [Google Scholar] [CrossRef]
- Maciak, E.; Pustelny, T. An optical ammonia (NH3) gas sensing by means of Pd/CuPc interferometric nanostructures based on white light interferometry. Sens. Actuators B Chem. 2013, 189, 230–239. [Google Scholar] [CrossRef]
- Hu, J.; Wang, L.; Zhang, P.; Liang, C.; Shao, G. Construction of solid-state Z-scheme carbon-modified TiO2/WO3 nanofibers with enhanced photocatalytic hydrogen production. J. Power Source 2016, 328, 28–36. [Google Scholar] [CrossRef]
- Li, Z.; Yang, M.; Dai, J.; Wang, G.; Huang, C.; Tang, J.; Hu, W.; Song, H.; Huang, P. Optical fiber hydrogen sensor based on evaporated Pt/WO3 film. Sens. Actuators B Chem. 2015, 206, 564–569. [Google Scholar] [CrossRef]
- Huang, B.-R.; Lin, T.-C.; Liu, Y.-M. WO3/TiO2 core-shell nanostructure for high performance energy-saving smart windows. Solar Energy Mater. Solar Cells 2015, 133, 32–38. [Google Scholar] [CrossRef]
- Tahir, M.B.; Sagir, M.; Shahzad, K. Removal of acetylsalicylate and methyl-theobromine from aqueous environment using nano-photocatalyst WO3-TiO2 @g-C3N4 composite. J. Hazard. Mater. 2019, 363, 205–213. [Google Scholar] [CrossRef] [PubMed]
- Wang, Y.; He, B.; Wang, H.; Xu, J.; Ta, T.; Li, W.; Wang, Q.; Yang, S.; Tang, Y.; Zou, B. Transparent WO3/Ag/WO3 electrode for flexible organic solar cells. Mater. Lett. 2017, 188, 107–110. [Google Scholar] [CrossRef]
- Faia, P.M.; Libardi, J. Response to humidity of TiO2:WO3 sensors doped with V2O5: Influence of fabrication route. Sens. Actuators B Chem. 2016, 236, 682–700. [Google Scholar] [CrossRef]
- Sun, J.; Sun, L.; Han, N.; Pan, J.; Liu, W.; Bai, S.; Feng, Y.; Luo, R.; Li, D.; Chen, A. Ordered mesoporous WO3/ZnO nanocomposites with isotype heterojunctions for sensitive detection of NO2. Sens. Actuators B Chem. 2019, 285, 68–75. [Google Scholar] [CrossRef]
- Hočevar, M.; Krašovec, U.O. Cubic WO3 stabilized by inclusion of Ti: Applicable in photochromic glazing. Solar Energy Mater. Solar Cells 2016, 154, 57–64. [Google Scholar] [CrossRef]
- Ataalla, M.; Afify, A.S.; Hassan, M.; Abdallah, M.; Milanova, M.; Aboul-Enein, H.Y.; Mohamed, A. Tungsten-based glasses for photochromic, electrochromic, gas sensors, and related applications: A review. J. Non-Cryst. Solids 2018, 491, 43–54. [Google Scholar] [CrossRef]
- Bange, K. Colouration of tungsten oxide films: A model for optically active coatings. Sol. Energy Mater. Sol. Cells 1999, 58, 1–131. [Google Scholar] [CrossRef]
- Vogt, T.; Woodward, P.M.; Hunter, B.A. The high-temperature phases of WO3. J. Solid State Chem. 1999, 144, 209–215. [Google Scholar] [CrossRef]
- Ahmad, M.Z.; Sadek, A.Z.; Yaacob, M.; Anderson, D.P.; Matthews, G.; Golovko, V.B.; Wlodarski, W. Optical characterisation of nanostructured Au/WO3 thin films for sensing hydrogen at low concentrations. Sens. Actuators B Chem. 2013, 179, 125–130. [Google Scholar] [CrossRef]
- Pandurang, A. Transition Metal Oxide Thin Film Based Chromogenics and Devices, 1st ed.; Elsevier: Amsterdam, The Netherlands, 2017. [Google Scholar]
- Opara Krašovec, U.; Šurca Vuk, A.; Orel, B. IR Spectroscopic studies of charged-discharged crystalline WO3 films. Electrochim. Acta 2001, 46, 1921–1929. [Google Scholar] [CrossRef]
- Inouye, A.; Yamamoto, S.; Nagata, S.; Yoshikawa, M.; Shikama, T. Hydrogen behavior in gasochromic tungsten oxide films investigated by elastic recoil detection analysis. Nucl. Instrum. Methods. Phys. Res. B 2008, 266, 301–307. [Google Scholar] [CrossRef]
- Gogova, D.; Thomas, L.-K.; Camin, B. Comparative study of gasochromic and electrochromic effect in thermally evaporated tungsten oxide thin films. Thin Solid Films 2009, 517, 3326–3331. [Google Scholar] [CrossRef]
- Domaradzki, J.; Kaczmarek, D.; Wojcieszak, D.; Mazur, M. Investigations of reversible optical transmission in gasochromic (Ti-V-Ta) Ox thin film for gas sensing applications. Sens. Actuators B Chem. 2014, 201, 420–425. [Google Scholar] [CrossRef]
- Liu, B.; Cai, D.; Liu, Y.; Wang, D.; Wang, L.; Wang, Y.; Li, H.; Li, Q.; Wang, T. Improved room-temperature hydrogen sensing performance of directly formed Pd/WO3 nanocomposite. Sens. Actuators B Chem. 2014, 193, 28–34. [Google Scholar] [CrossRef]
- Sanger, A.; Kumar, A.; Kumar, A.; Jaiswal, J.; Chandra, R. A fast response/recovery of hydrophobic Pd/V2O5 thin films for hydrogen gas sensing. Sens. Actuators B Chem. 2016, 236, 16–26. [Google Scholar] [CrossRef]
- Rizzo, G.; Arena, A.; Bonavita, A.; Donato, N.; Neri, G.; Saitta, G. Gasochromic response of nanocrystalline vanadium pentoxide films deposited from ethanol dispersions. Thin Solid Films 2010, 518, 7124–7127. [Google Scholar] [CrossRef]
- Ho, Y.; Chang, C.; Wei, D.; Dong, C.; Chen, C.; Chen, J.; Jang, W.; Hsu, C.; Chan, T.; Kumar, K. Characterization of gasochromic vanadium oxides films by X-ray absorption spectroscopy. Thin Solid Films 2013, 544, 461–465. [Google Scholar] [CrossRef]
- Shanak, H.; Schmitt, H.; Nowoczin, J.; Ehses, K.-H. Effect of O2 partial pressure and thickness on the gasochromic properties of sputtered V2O5 films. J. Mater. Sci. 2005, 40, 3467–3474. [Google Scholar] [CrossRef]
- Jang, W.-L.; Lu, Y.-M.; Lu, Y.-R.; Chen, C.-L.; Dong, C.-L.; Chou, W.-C.; Chen, J.-L.; Chan, T.-S.; Lee, J.-F.; Pao, C.-W. Effects of oxygen partial pressure on structural and gasochromic properties of sputtered VOx thin films. Thin Solid Films 2013, 544, 448–451. [Google Scholar] [CrossRef]
- Hosseini, M.; Ranjbar, M. Plasmonic Au-MoO3 colloidal nanoparticles by reduction of HAuCl4 by blue MoOx nanosheets and observation of the gasochromic property. Plasmonics 2018, 13, 1897–1906. [Google Scholar] [CrossRef]
- Kalanur, S.S.; Yoo, I.-H.; Seo, H. Pd on MoO3 nanoplates as small-polaron-resonant eye-readable gasochromic and electrical hydrogen sensor. Sens. Actuators B Chem. 2017, 247, 357–365. [Google Scholar] [CrossRef]
- Chang, C.-C.; Luo, J.-Y.; Chen, T.-K.; Yeh, K.-W.; Huang, T.-W.; Hsu, C.-H.; Chao, W.-H.; Ke, C.-T.; Hsu, P.-C.; Wang, M.-J. Pulsed laser deposition of (MoO3)1-x (V2O5)x thin films: Preparation, characterization and gasochromic studies. Thin Solid Films 2010, 519, 1552–1557. [Google Scholar] [CrossRef]
- Imani, M.; Tadjarodi, A. H2S gasochromic effect of mixed ammonium salts of phosphomolybdate nanoparticles synthesized by microwave assisted technique. Sens. Actuators B Chem. 2016, 237, 715–723. [Google Scholar] [CrossRef]
- Fomanyuk, S.; Kolbasov, G.Y.; Chernii, V.Y.; Tretyakova, I. Gasochromic α, β–Ni (OH)2 films for the determination of CO and chlorine content. Sens. Actuators B Chem. 2017, 244, 717–726. [Google Scholar] [CrossRef]
- Orel, B.; Grošelj, N.; Krašovec, U.O.; Gabršček, M.; Bukovec, P.; Reisfeld, R. Gasochromic effect of palladium doped peroxopolytungstic acid films prepared by the sol-gel route. Sens. Actuators B Chem. 1998, 50, 234–245. [Google Scholar] [CrossRef]
- Orel, B.; Krašovec, U.O.; Grošelj, N.; Kosec, M.; Dražič, G.; Reisfeld, R. Gasochromic behavior of sol-gel derived Pd doped peroxopolytungstic acid (W-PTA) nano-composite films. J. Sol-Gel Sci. Technol. 1999, 14, 291–308. [Google Scholar] [CrossRef]
- Ngene, P.; Radeva, T.; Slaman, M.; Westerwaal, R.J.; Schreuders, H.; Dam, B. Seeing hydrogen in colors: Low-cost and highly sensitive eye readable hydrogen detectors. Adv. Funct. Mater. 2014, 24, 2374–2382. [Google Scholar] [CrossRef]
- Seo, C.; Cheong, H.; Lee, S.-H. Color change of V2O5 thin films upon exposure to organic vapors. Sol. Energy Mater. Sol. Cells 2008, 92, 190–193. [Google Scholar] [CrossRef]
- Peter, C.; Schmitt, K.; Apitz, M.; Woellenstein, J. Metallo-porphyrin zinc as gas sensitive material for colorimetric gas sensors on planar optical waveguides. Microsyst. Technol. 2012, 18, 925–930. [Google Scholar] [CrossRef]
- Xu, B.; Xu, L.; Gao, G.; Li, Z.; Liu, Y.; Guo, W.; Jia, L. Polyoxometalate-based gasochromic silica. New J. Chem 2008, 32, 1008–1013. [Google Scholar] [CrossRef]
- Wang, Z.; Yuan, X.; Cong, S.; Chen, Z.; Li, Q.; Geng, F.; Zhao, Z. Color-changing microfiber-based multifunctional window screen for capture and visualized monitoring of NH3. ACS Appl. Mater. Interfaces 2018, 10, 15065–15072. [Google Scholar] [CrossRef] [PubMed]
- Shim, G.; Lee, S.Y.; Kalanur, S.S.; Seo, H.J. Eye-readable gasochromic and electrical detectability of hydrogenated Pd-TiO2 to gaseous fluorine species. Appl. Surf. Sci. 2018, 462, 791–798. [Google Scholar] [CrossRef]
- Hakoda, T.; Igarashi, H.; Isozumi, Y.; Yamamoto, S.; Aritani, H.; Yoshikawa, M. Gasochromic property of dehydrogenation-catalyst loaded tungsten trioxide. J. Phys. Chem. Solids 2013, 74, 200–204. [Google Scholar] [CrossRef]
- Okumu, J.; Koerfer, F.; Salinga, C.; Pedersen, T.; Wuttig, M. Gasochromic switching of reactively sputtered molybdenumoxide films: A correlation between film properties and deposition pressure. Thin Solid Films 2006, 515, 1327–1333. [Google Scholar] [CrossRef]
- Deb, S.K. Optical and photoelectric properties and colour centres in thin films of tungsten oxide. Philos. Mag. 1973, 27, 801–822. [Google Scholar] [CrossRef]
- Ito, K.; Ohgami, T. Hydrogen detection based on coloration of anodic tungsten oxide film. Appl. Phys. Lett. 1992, 60, 938–940. [Google Scholar] [CrossRef]
- Krašovec, U.O.; Orel, B.; Georg, A.; Wittwer, V. The gasochromic properties of sol-gel WO3 films with sputtered Pt catalyst. Sol. Energy 2000, 68, 541–551. [Google Scholar] [CrossRef]
- Hemati, M.A.; Ranjbar, M.; Kameli, P.; Salamati, H. Gasochromic tungstenoxide films with PdCl2 solution as an aqueous hydrogen catalyst. Sol. Energy Mater. Sol. Cells 2013, 108, 105–112. [Google Scholar] [CrossRef]
- Salinga, C.; Weis, H.; Wuttig, M. Gasochromic switching of tungsten oxide films: A correlation between film properties and coloration kinetics. Thin Solid Films 2002, 414, 288–295. [Google Scholar] [CrossRef]
- Hsu, W.-C.; Peng, C.-H.; Chang, C.-C. Hydrogen sensing characteristics of an electrodeposited WO3 thin film gasochromic sensor activated by Pt catalyst. Thin Solid Films 2007, 516, 407–411. [Google Scholar] [CrossRef]
- Zayat, M.; Reisfeld, R.; Minti, H.; Orel, B.; Svegl, F. Gasochromic effect in platinum-doped tungsten trioxide films prepared by the sol-gel method. J. Sol-Gel Sci. Technol. 1998, 11, 161–168. [Google Scholar] [CrossRef]
- Orel, B.; Grošelj, N.; Krašovec, U.O.; Ješe, R.A.; Georg, A. IR spectroscopic investigations of gasochromic and electrochromic sol-gel-derived peroxotungstic acid/ormosil composite and crystalline WO3 films. J. Sol.-Gel. Sci. Technol. 2002, 24, 5–22. [Google Scholar] [CrossRef]
- Garavand, N.T.; Mahdavi, S.; Ranjbar, M. The effect of operating temperature on gasochromic properties of amorphous and polycrystalline pulsed laser deposited WO3 films. Sens. Actuators B Chem. 2012, 169, 284–290. [Google Scholar] [CrossRef]
- Ando, M. Recent advances in optochemical sensors for the detection of H2, O2, O3, CO, CO2 and H2O in air. TrAC Trends Anal. Chem. 2006, 25, 937–948. [Google Scholar] [CrossRef]
- Chan, C.-C.; Hsu, W.-C.; Chang, C.-C.; Hsu, C.-S. Hydrogen incorporation in gasochromic coloration of sol–gel WO3 thin films. Sens. Actuators B Chem. 2011, 157, 504–509. [Google Scholar] [CrossRef]
- Chen, H.; Xu, N.; Deng, S.; Lu, D.; Li, Z.; Zhou, J.; Chen, J. Gasochromic effect and relative mechanism of WO3 nanowire films. Nanotechnology 2007, 18, 205701. [Google Scholar] [CrossRef]
- Kalhori, H.; Ranjbar, M.; Salamati, H.; Coey, J. Flower-like nanostructures of WO3: Fabrication and characterization of their in-liquid gasochromic effect. Sens. Actuators B Chem. 2016, 225, 535–543. [Google Scholar] [CrossRef]
- Georg, A.; Graf, W.; Neumann, R.; Wittwer, V. Mechanism of the gasochromic coloration of porous WO3 films. Solid State Ion. 2000, 127, 319–328. [Google Scholar] [CrossRef]
- Yamamoto, S.; Inouye, A.; Yoshikawa, M. Structural and gasochromic properties of epitaxial WO3 films prepared by pulsed laser deposition. Nucl. Instrum. Methods Phys. Res. B 2008, 266, 802–806. [Google Scholar] [CrossRef]
- Behbahani, M.A.; Ranjbar, M.; Kameli, P.; Salamati, H. Hydrogen sensing by wet-gasochromic coloring of PdCl2 (aq)/WO3 and the role of hydrophilicity of tungsten oxide films. Sens. Actuators B Chem. 2013, 188, 127–136. [Google Scholar] [CrossRef]
- Garavand, N.T.; Mahdavi, S. Pt and Pd as catalyst deposited by hydrogen reduction of metal salts on WO3 films for gasochromic application. Appl. Surf. Sci. 2013, 273, 261–267. [Google Scholar] [CrossRef]
- Lee, S.-H.; Cheong, H.M.; Liu, P.; Smith, D.; Tracy, C.E.; Mascarenhas, A.; Pitts, J.R.; Deb, S.K. Raman spectroscopic studies of gasochromic a-WO3 thin films. J. Electrochim. Acta 2001, 46, 1995–1999. [Google Scholar] [CrossRef]
- Lee, Y.-A.; Kalanur, S.S.; Shim, G.; Park, J.; Seo, H. Highly sensitive gasochromic H2 sensing by nano-columnar WO3-Pd films with surface moisture. Sens. Actuators B Chem. 2017, 238, 111–119. [Google Scholar] [CrossRef]
- Shanak, H.; Schmitt, H. Fast coloration in sputtered gasochromic tungsten oxide films. J. Phys. Status Solidi 2006, 203, 3748–3753. [Google Scholar] [CrossRef]
- Nishizawa, K.; Yamada, Y.; Yoshimura, K. Low-temperature chemical fabrication of Pt-WO3 gasochromic switchable films using UV irradiation. Sol. Energy Mater. Sol. Cells 2017, 170, 21–26. [Google Scholar] [CrossRef]
- Kalanur, S.S.; Heo, J.; Yoo, I.-H.; Seo, H. 2-D WO3 decorated with Pd for rapid gasochromic and electrical hydrogen sensing. Int. J. Hydrogen Energy 2017, 42, 16901–16908. [Google Scholar] [CrossRef]
- Zamharir, S.G.; Ranjbar, M.; Salamati, H. Excimer laser treatment of TiO2/WO3 thin films for self-cleaning gasochromic applications: Preparation and characterization. Sol. Energy Mater. Sol. Cells 2014, 130, 27–35. [Google Scholar] [CrossRef]
- Yamaguchi, Y.; Emoto, Y.; Kineri, T.; Fujimoto, M.; Mae, H.; Yasumori, A.; Nishio, K.J. Hydrogen gas-sensing properties of Pt/WO3 thin film in various measurement conditions. Ionics 2012, 18, 449–453. [Google Scholar] [CrossRef]
- Kalanur, S.S.; Yoo, I.-H.; Lee, Y.-A.; Seo, H. Green deposition of Pd nanoparticles on WO3 for optical, electronic and gasochromic hydrogen sensing applications. Sens. Actuators B Chem. 2015, 221, 411–417. [Google Scholar] [CrossRef]
- Kim, J.-H.; Mirzaei, A.; Kim, H.W.; Kim, S.S. Low power-consumption CO gas sensors based on Au-functionalized SnO2-ZnO core-shell nanowires. Sens. Actuators B Chem. 2018, 267, 597–607. [Google Scholar] [CrossRef]
- Chen, S.; Luo, J.; Tan, H.; Chen, J.; Deng, S.; Xu, N. Study of self-heating phenomenon and its resultant effect on ultrafast gasochromic coloration of Pt-WO3 nanowire films. Sens. Actuators B Chem. 2012, 173, 824–832. [Google Scholar] [CrossRef]
- Okazaki, S.; Johjima, S. Temperature dependence and degradation of gasochromic response behavior in hydrogen sensing with Pt/WO3 thin film. Thin Solid Films 2014, 558, 411–415. [Google Scholar] [CrossRef]
- Luo, J.Y.; Deng, S.Z.; Tao, Y.T.; Zhao, F.L.; Zhu, L.F.; Gong, L.; Chen, J.; Xu, N.S. Evidence of localized water molecules and their role in the gasochromic effect of WO3 nanowire films. J. Phys. Chem. C 2009, 113, 15877–15881. [Google Scholar] [CrossRef]
- Luo, J.Y.; Gong, L.; Tan, H.D.; Deng, S.Z.; Xu, N.S.; Zeng, Q.G.; Wang, Y. Study of the catalyst poisoning and reactivation of Pt nanoparticles on the surface of WO3 nanowire in gasochromic coloration. Sens. Actuators B Chem. 2012, 171, 1117–1124. [Google Scholar] [CrossRef]
- Foroushani, F.T.; Tavanai, H.; Ranjbar, M.; Bahrami, H. Fabrication of tungsten oxide nanofibers via electrospinning for gasochromic hydrogen detection. Sens. Actuators B Chem. 2018, 268, 319–327. [Google Scholar] [CrossRef]
- Wisitsoorat, A.; Ahmad, M.; Yaacob, M.; Horpratum, M.; Phakaratkul, D.; Lomas, T.; Tuantranont, A.; Wlodarski, W. Optical H2 sensing properties of vertically aligned Pd/WO3 nanorods thin films deposited via glancing angle rf magnetron sputtering. Sens. Actuators B Chem. 2013, 182, 795–801. [Google Scholar] [CrossRef]
- Chan, C.-C.; Hsu, W.-C.; Chang, C.-C.; Hsu, C.-S. Preparation and characterization of gasochromic Pt/WO3 hydrogen sensor by using the Taguchi design method. Sens. Actuators B Chem. 2010, 145, 691–697. [Google Scholar] [CrossRef]
- Hsu, C.-H.; Chang, C.-C.; Tseng, C.-M.; Chan, C.-C.; Chao, W.-H.; Wu, Y.-R.; Wen, M.-H.; Hsieh, Y.-T.; Wang, Y.-C.; Chen, C.-L. An ultra-fast response gasochromic device for hydrogen gas detection. Sens. Actuators B Chem. 2013, 186, 193–198. [Google Scholar] [CrossRef]
- Chen, M.; Zou, L.; Zhang, Z.; Shen, J.; Li, D.; Zong, Q.; Gao, G.; Wu, G.; Zhang, Z. Tandem gasochromic-Pd-WO3/graphene/Si device for room-temperature high-performance optoelectronic hydrogen sensors. Carbon 2018, 130, 281–287. [Google Scholar] [CrossRef]
- Yamaguchi, Y.; Imamura, S.; Ito, S.; Nishio, K.; Fujimoto, K. Influence of oxygen gas concentration on hydrogen sensing of Pt/WO3 thin film prepared by sol-gel process. Sens. Actuators B Chem. 2015, 216, 394–401. [Google Scholar] [CrossRef]
- Schweiger, D.; Georg, A.; Graf, W.; Wittwer, V. Examination of the kinetics and performance of a catalytically switching (gasochromic) device. Solar Energy Mater. Solar Cells 1998, 54, 99–108. [Google Scholar] [CrossRef]
- Ranjbar, M.N.; Garavand, T.; Mahdavi, S. Electroless plating of palladium on WO3 films for gasochromic applications. J. Sol. Energy Mater. Sol. Cells 2010, 94, 201–206. [Google Scholar] [CrossRef]
- Yamamoto, S.; Takano, K.; Inouye, A.; Yoshikawa, M. Effects of composition and structure on gasochromic coloration of tungsten oxide films investigated with XRD and RBS. Nucl. Instrum. Methods Phys. Res. B 2007, 262, 29–32. [Google Scholar] [CrossRef]
- Hsu, C.-H.; Chang, C.-C.; Yeh, K.-W.; Wu, Y.-R.; Chan, C.-C.; Wang, M.-J.; Wu, M.-K. Pulsed laser deposition of (WO3)1-x (Nb2O5)x thin films: Characterization and gasochromic studies. Thin Solid Films 2011, 520, 1470–1474. [Google Scholar] [CrossRef]
- Ranjbar, M.; Mahdavi, S. Pulsed laser deposition of W-V-O composite films: Preparation, characterization and gasochromic studies. Sol. Energy Mater. Sol. Cells 2008, 92, 878–883. [Google Scholar] [CrossRef]
- Ranjbar, M.; Fardindoost, S.; Mahdavi, A.I. Palladium nanoparticle deposition onto the WO3 surface through hydrogen reduction of PdCl2: Characterization and gasochromic properties. Sol. Energy Mater. Sol. Cells 2011, 95, 2335–2340. [Google Scholar] [CrossRef]
- Garavand, N.T.; Mahdavi, S. Pd2+ reduction and gasochromic properties of colloidal tungsten oxide nanoparticles synthesized by pulsed laser ablation. Appl. Phys. A 2012, 108, 401–407. [Google Scholar] [CrossRef]
- Li, J.; Zhao, Q.-L.; Zhang, G.-Y.; Chen, J.-Z.; Zhong, L.; Li, L.; Huang, J.; Ma, Z. Synthesis of monoclinic WO3 nanosphere hydrogen gasochromic film via a sol-gel approach using PS-b-PAA diblock copolymer as template. Solid State Sci. 2010, 12, 1393–1398. [Google Scholar] [CrossRef]
- Li, D.; Wu, G.; Gao, G.; Shen, J.; Huang, F. Ultrafast coloring-bleaching performance of nanoporous WO3–SiO2 gasochromic films doped with Pd catalyst. ACS Appl. Mater. Interfaces 2011, 3, 4573–4579. [Google Scholar] [CrossRef]
- Castillero, P.; Rico-Gavira, V.; Lopez-Santos, C.; Barranco, A.; Perez-Dieste, V.; Escudero, C.; Espinós, J.P.; González-Elipe, A.N.R. Formation of subsurface W5+ species in gasochromic Pt/WO3 thin films exposed to hydrogen. J. Phys. Chem. C 2017, 121, 5719–15727. [Google Scholar] [CrossRef]

© 2019 by the authors. Licensee MDPI, Basel, Switzerland. This article is an open access article distributed under the terms and conditions of the Creative Commons Attribution (CC BY) license (http://creativecommons.org/licenses/by/4.0/).
Share and Cite
Mirzaei, A.; Kim, J.-H.; Kim, H.W.; Kim, S.S. Gasochromic WO3 Nanostructures for the Detection of Hydrogen Gas: An Overview. Appl. Sci. 2019, 9, 1775. https://doi.org/10.3390/app9091775
Mirzaei A, Kim J-H, Kim HW, Kim SS. Gasochromic WO3 Nanostructures for the Detection of Hydrogen Gas: An Overview. Applied Sciences. 2019; 9(9):1775. https://doi.org/10.3390/app9091775
Chicago/Turabian StyleMirzaei, Ali, Jae-Hun Kim, Hyoun Woo Kim, and Sang Sub Kim. 2019. "Gasochromic WO3 Nanostructures for the Detection of Hydrogen Gas: An Overview" Applied Sciences 9, no. 9: 1775. https://doi.org/10.3390/app9091775
APA StyleMirzaei, A., Kim, J.-H., Kim, H. W., & Kim, S. S. (2019). Gasochromic WO3 Nanostructures for the Detection of Hydrogen Gas: An Overview. Applied Sciences, 9(9), 1775. https://doi.org/10.3390/app9091775







